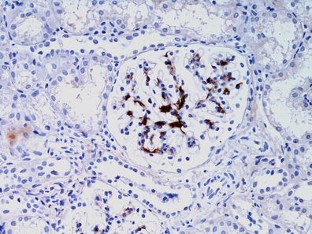

Abstract
Background
C1q nephropathy has been suggested as a separate disease entity. C1q positivity has also been described in association with nephrotic syndrome (NS) as a potential marker for worse outcome. The aims of this study were to describe the clinical characteristics, laboratory parameters and outcomes of 35 children whose renal histology revealed predominant mesangial C1q deposition and to investigate if the experience at our institution supports the above hypothesis.
Method
Clinical and pathological characteristics of all children whose kidney biopsies showed positive C1q staining were retrospectively recorded. The outcome of children with minimal change nephrotic syndrome (MCNS) and predominant mesangial C1q deposition based on C1q staining was compared with that of a concurrent group of children with MCNS with no such immune staining.
Results
The median age of the patient cohort was 4.5 years (range 6 months to 16 years), 69 % were boys and 88 % presented with nephrotic syndrome (NS). Children with C1q staining and MCNS had more relapses (p = 0.001) and shorter relapse-free periods (p = 0.033) than those with negative immunostaining, but the long-term outcomes were similar in both groups.
Conclusion
Our data do not support C1q nephropathy as a separate diagnostic category. Children with MCNS and mesangial C1q deposition (staining) showed more relapses but no difference in long term renal outcome.
Similar content being viewed by others
References
Wenderfer SE, Swinford RD, Braun MC (2010) C1q nephropathy in the pediatric population: pathology and pathogenesis. Pediatr Nephrol 25:1385–1396
Mii A, Shimizu A, Masuda Y, Fujita E, Aki K, Ishizaki M, Sato S, Griesemer A, Fukuda Y (2009) Current status and issues of C1q nephropathy. Clin Exp Nephrol 13:263–274
JenneteJC HCG (1985) C1q nephropathy: a distinct pathologic entity usually causing nephrotic syndrome. Am J Kidney Dis 6:103–110
Wong CS, Fink CA, Baechle J, Harris AA, Staples AO, Brandt JR (2009) C1q nephropathy and minimal change nephrotic syndrome. Pediatric Nephrol 24:761–767
Markowitz GS, Schwimmer JA, Stokes MB, Nasr S, Seigle RL, Valeri Am, D‘Agati VD (2003) C1q nephropathy: a variant of focal segmental glomerulosclerosis. Kidney Int 64:1232–1240
Hisano S, Fukuma Y, Segawa Y, Niimi K, Kaku Y, Hatae K, Saitoh T, Takeshita M, Iwasaki H (2008) Clinicopathologic correlation and outcome of C1qNephropathy. Clin J Am Soc Nephrol 3:1637–1643
Berger SP, Roos A, Daha MR (2005) Complement and the kidney: what the nephrologists needs to know in 2006? Nephrol Dial Transplant 20:2613–2619
Jennette JC, Hipp CG (1985) Immunohistopathologic evaluation of C1q in 800 renal biopsy specimens. Am J Clin Pathol 83:415–420
Iskandar SS, Browning MC, Lorentz WB (1991) C1q Nephropathy: a pediatric clinicopathologic study. Am J Kidney Dis 18:459–465
Lau KK, Gaber LW, Santos NMD, Wyatt RJ (2005) C1q nephropathy: features at presentation and outcome. Pediatr Nephrol 20:744–749
Fukuma Y, Hisano S, Segawa Y, Niimi K, Tsuru N, Kaku Y, Hatae K, Kiyoshi Y, Mitsudome A, Iwasaki H (2006) Clinicopathologic correlation of C1q nephropathy in children. Am J Kidney Dis 47:412–418
Vizjak A, Ferluga D, Rožič M, Hvala A, Lindič J, Levart TK, Jurcic V, Jennette JC (2008) Pathology, clinical presentations, and outcomes of C1q nephropathy. J Am Soc Nephrol 19:2237–2244
Acknowledgments
NJS is part supported by the NIHR GOSH BRC and GOSHCC. The results presented in this study have not been published previously in whole or part. The authors would like to thank Mr. Sarath Gamage for his support with statistical analysis.
Conflict of interest
None.
Author information
Authors and Affiliations
Corresponding author
Rights and permissions
About this article
Cite this article
Gunasekara, V.N., Sebire, N.J. & Tullus, K. C1q nephropathy in children: clinical characteristics and outcome. Pediatr Nephrol 29, 407–413 (2014). https://doi.org/10.1007/s00467-013-2692-4
Received:
Revised:
Accepted:
Published:
Issue Date:
DOI: https://doi.org/10.1007/s00467-013-2692-4




